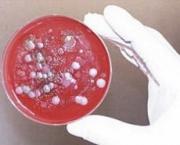
Двое ставропольцев госпитализированы с подозрением на сибирскую язву

Тег: Госпитализирован

Жительница Ставрополья погибла от отравления угарным газом, ещё четверо госпитализированы
В селе Камбулат Туркменского района 25 января в результате отравления угарным газом в одном из частных домов скончалась женщина, ещё четверо человек г...

Госпитализированных школьников из села Александровского выписали из больницы
Напомним, в школе №2 села Александровского в конце минувшей недели были госпитализированы 45 человек. По информации краевого министерства здравоохране...
Двое ставропольцев госпитализированы с подозрением на сибирскую язву
По информации Роспотребнадзора по Ставропольскому краю у двух жителей поселка Солнечнодольска Изобильненского района зарегистрировано заболевание с п...

Актриса Нина Дорошина срочно госпитализирована
Знаменитая советская актриса, народная артистка РСФСР Нина Дорошина угодила в Боткинскую больницу. Об этом рассказали представители медицинского учреж...

Анита Цой срочно госпитализирована из-за грима
Популярная отечественная певица Анита Цой на днях была срочно госпитализирована в одну из столичных больниц. Это произошло сразу после съемок известно...

Срочно госпитализирован Владимир Этуш
Известный русский актер Владимир Этуш был экстренно госпитализирован в одну из столичных больниц с томным болезнью. У 90-летнего артиста зафиксировано...

Создатель АК-47 госпитализирован в реанимацию
Миша Калашников госпитализирован в реанимацию, о этом сказал его помошник Николай Шкляев. Калашников лёг на плановое обследование, но во время обслед...

Леонид Броневой срочно госпитализирован с инфарктом
Прославленный актер Леонид Броневой был безотлагательно госпитализирован в реанимацию одной из больниц Киева, когда его сразил инфаркт...

Юлия Началова госпитализирована в США
Знаменитая русская певица Юлия Началова была безотлагательно госпитализирована прямо из аэропорта Лос-Анджелеса. 31-летняя артистка, которая не так да...

Хэлли Берри срочно госпитализирована
Прямо со съемочной площадки, где следует работа над фильмом "Улей", с суровой травмой головы в лос-анджелесскую клинику госпитализирована 46-летняя...

В результате ДТП госпитализирован Константин Лавроненко
Чрезвычайно беспокойная новость пришла со съемочной площадки телесериала "Стоимость жизни": работа над фильмом приостановлена по причине критическог...

Беременная Маша Распутина срочно госпитализирована
Известная певица Маша Распутина на самом деле ожидает малыша. Извещение о этом возникло накануне в прессе, но в тот момент все преподносилось на уровн...

Певица Нюша экстренно госпитализирована
В столичном аэропорту Домодедово юная артистка растеряла сознание. Реамобиль доставил Нюшу в одну из приватных клиник Москвы. Лекари пока не предостав...

Геннадий Зюганов экстренно госпитализирован в Кисловодске
Фаворит коммунистов Геннадий Зюганов безотлагательно доставлен в клинику с сердечным приступом, извещает Lifenews.Геннадий Зюганов был госпитализирова...

В Петербурге срочно госпитализирован Эдуард Хиль
Прославленный 77-летний певец Эдуард Хиль экстренно госпитализирован в клинику Санкт-Петербургу. Его состояние лекари расценивают как тяжелое. По подг...

Срочно госпитализирована Ирина Агибалова
Ира Агибалова-старшая с телепроекта "Дом-2" была в срочном порядке доставлена в мед учреждение. Что непосредственно случилось с одной из самых обгов...

Дочь Уитни Хьюстон срочно госпитализирована
Опосля того как вчера в 15:55 южноамериканские лекари, приехавшие на вызов в гостиницу, где скончалась знаменитая певица Уитни Хьюстон, констатировали...

Сергей Сафронов экстренно госпитализирован
Братья Сафроновы, являющиеся одними из самых известных русских иллюзионистов и бессменные скептики шоу "Битва экстрасенсов", еще в начале января это...

Михаил Державин госпитализирован в Москве
Прославленный русский актер театра и кино Миша Державин накануне был экстренно госпитализирован в одну из столичных больниц. У любимого артиста лекари...

Актер Александр Носик экстренно госпитализирован
Знаменитый русский актер Александр Носик, который прославился по телесериалу "Возвращение Мухтара", накануне был безотлагательно доставлен в одну из...

Игорь Кваша экстренно госпитализирован
На днях 78-летнего знаменитого актера и телеведущего Игоря Квашу безотлагательно госпитализировали в томном состоянии. У Игоря Владимировича произошел...

Двое пострадавших при пожаре на "Ставроплене" госпитализированы
Двое пострадавших в итоге пожара на местности ООО "Ставролен" госпитализированы в центральную районную Буденновскую клинику Ставропольского края, из...

Николай Караченцов экстренно госпитализирован
Известный русский и русский актер, певец Николай Караченцов был безотлагательно госпитализирован. Его поместили в НИИ имени Склифосовского в Москве из...

Актриса Юлия Борисова срочно госпитализирована
Известная русская актриса Юлия Борисова, которая нашла всемирную славу благодаря собственной прекрасной игре, как на экранах, так и во почти всех спек...

Алла Пугачева срочно госпитализирована
В прошедшее воскресенье, 62-летняя Алла Пугачева неожиданно ощутила себя плохо и сходу же обратилась за поддержкою к квалифицированным докторам в Науч...

Джордж Майкл госпитализирован
Джордж Майкл, знаменитый английский исполнитель, сейчас ночкой, 24 ноября, госпитализирован в одну из венских больниц. По известиям евро телеканала Sk...

Евгений Жариков срочно госпитализирован
Знаменитый русский русский актер Евгений Жариков был безотлагательно доставлен в одну из приватных клиник Москвы. 70-летнего артиста госпитализировали...

Владимир Машков срочно госпитализирован
Знаменитый в Рф и не лишь актер Владимир Машков с недавних пор кроме собственной главной деятельности, занялся еще и политическими баталиями...

Элтон Джон экстренно госпитализирован
Известный английский певец сэр Элтон Джон накануне был безотлагательно доставлен в клинику с недоверием на кишечную инфекцию. По данной причине артист...

В Москве экстренно госпитализирован Марлен Хуциев
Известный кинорежиссер Марлен Хуциев несколько дней назад был экстренно доставлен в одну из столичных больниц. Врачи диагностировали у известного режи...

Актер Валентин Гафт экстренно госпитализирован
Знаменитый актер, народный артист РСФСР Валентин Гафт был безотлагательно госпитализирован в институт имени Склифосовского в Москве...

Разыскивается водитель, по вине которого один пешеход погиб, другой госпитализирован
Ночкой 25 сентября, предположительно в 01.28, в грам. Ставрополе шофер Тойоты Камри, двигаясь по ул. Тухачевского со стороны ул. Доваторцев в сторону...

Художник Борис Краснов срочно госпитализирован
Знаменитый художник-декоратор Борис Краснов, оговариваемый в вымогательстве, был госпитализирован в центр имени Бурназяна.Живописец попал в клинику оп...

Певица Лайма Вайкуле срочно госпитализирована
Известную латвийскую певицу Лайму Вайкуле госпитализировали в одну из больниц Москвы с переломом руки.1 июля женщина получила травму во время неудачно...

Срочно госпитализирован Игорь Крутой
Популярный российский композитор и продюсер Игорь Крутой ощутил резкую слабость во время футбольного матча "Шахтер" - "Рома", который состоялся на...

Валерия срочно госпитализирована
Популярная российская певица Валерия попала в больницу. Звезда шоу-бизнеса была срочно доставлена в областную екатеринбургскую больницу с температурой...

Маша Малиновская срочно госпитализирована
Известная российская телеведущая Маша Малиновская была доставлена в Институт Склифосовского. Звезда шоу-бизнес, которая ждет своего первенца, получила...

Шесть школьниц госпитализированы после пробы Манту
6 учениц седьмого класса школы в пгт Симеиз (Большая Ялта, Крым) госпитализированы в пятницу после проведения туберкулиновой пробы (реакция Манту)...

Чарли Шин срочно госпитализирован
Известный голливудский актер Чарли Шин был доставлен в клинику на «Скорой».Актер был госпитализирован в медицинский центр Cedars-Sinai в Беверли-Хиллз...

Лариса Удовиченко экстренно госпитализирована
Народная артистка России Лариса Удовиченко срочно доставлена в отделение реанимации Боткинской больницы Москвы. 55-летняя звезда была вынуждена обрати...

Наталья Варлей срочно госпитализирована
Российская актриса Наталья Варлей, известная по таким картинам как «Кавказская пленница», «Вий» и «Золото», попала в больницу...

Актёр Андрей Соколов госпитализирован с предположительно огнестрельным ранением
Вчера вечером, актёр театра «Ленком» Андрей Соколов был госпитализирован в НИИ имени Склифосовского, где ему была оказана первая медицинская помощь...

В Москве госпитализирован актер Юрий Яковлев
В российской столицы был госпитализирован народный артист СССР Юрий Яковлев. Его состояние оценивается медиками как стабильное и угрозы жизни нет. "Ю...

Алла Пугачева экстренно госпитализирована в Москве
Известная во всем мире певица Алла Пугачева сегодня, 22 декабря, почувствовала резкое недомогание и была немедленно доставлена в одну из элитных клини...

Актер Николай Добрынин срочно госпитализирован
Популярный российский актер Николай Добрынин угодил в больницу, когда почувствовал сильную боль. Неприятная история с актером случилась в минувшее вос...

Телеведущая Татьяна Веденеева госпитализирована в Москве
Популярная российская телеведущая Татьяна Веденеева в ночь с пятницы на субботу почувствовала резкое недомогание и была экстренно госпитализирована в...

Жан-Клод Ван Дамм срочно госпитализирован
Знаменитый актер Жан-Клод Ван Дамм был срочно госпитализирован В Новом Орлеане.Актер почувствовал себя плохо, в результате чего пришлось приостановить...

Людмила Касаткина срочно госпитализирована
Знаменитая актриса Людмила Касаткина, известная по легендарному фильму «Укротительница тигров», попала в больницу.Актриса была срочно доставлена в Цен...

Людмила Касаткина госпитализирована в Москве
Известная советская и российская актриса Людмила Касаткина была экстренно госпитализирована во вторник ранним утром из-за ухудшения состояния здоровья...

Госпитализированы еще семь детей из крымской школы
На протяжении минувшей субботы в инфекционное отделение Евпаторийской детской клинической больницы с предварительным диагнозом острая кишечная инфекци...